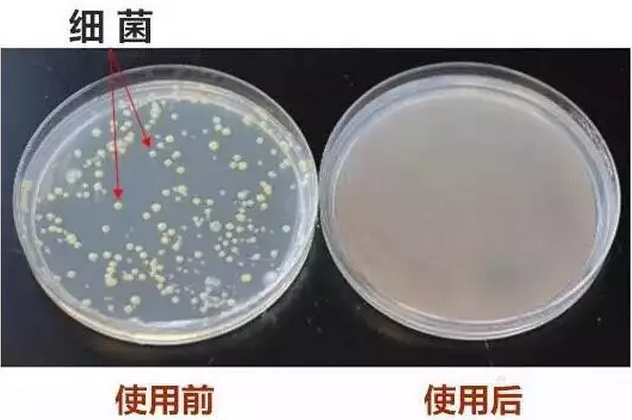
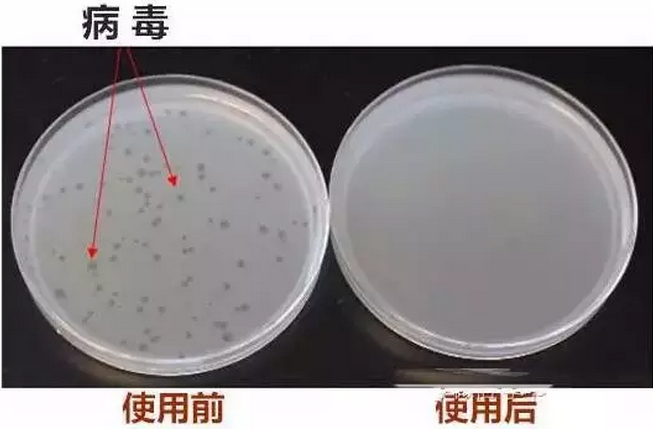

央视报道视频,
即便没有WiFi也要看完。
有人说净水器太贵啦!
我说,不是净水器太贵,
而是在你的眼里健康不值钱。
吃一顿大餐300元,
不贵,也就管一顿。
抽一盒烟四五十元,
也就只抽一天。
买一件衣服1000元,
不贵,就穿一季。
买个手机五六千元,
不贵,就用2年。
说到健康你就不重视,
一部手机的钱就可以买台完美净水器。
如果健康没有了,
其余的都是‘0’,
温馨提示你,
为了家人和孩子的健康,
再穷也要装一台净水器!
央视终于直接发话了
现阶段解决水污染的有效途径
就是安装一台净水器!

还要犹豫吗?
为了家人的身体负责
为了家人的身体健康,
每个家庭都需要健康
需要一台净水器!
金伟连牌净水机视频介绍
您知道海罗净吗?
他是一种新型高效杀菌滤芯
它源自美国的专利技术,有效杀死细菌和病毒,确保无细菌二次污染。你所知道的海罗净杀菌滤芯仅仅只是这样吗?NONONO!海罗净杀菌滤芯,远比你想象中更强大!
海罗净杀菌技术发明人——杰夫博士

杰夫博士有着在世界各地工作的多年经历,在目睹太多因饮用水不洁引发的疾病后,尤其在发展中国家,杰夫先生决心研制一种全新的高效,安全的杀菌材料。
此后杰夫先生召集一个由众多化学,微生物学及工程学领域内的博士,硕士组成的科研团队,历经十几年研发成“海罗净”材料,并获得美国最严格卫生安全组织—美国环保署(EPA)和国家卫生基金会(NSF)的许可。
杰夫博士和您谈谈
海罗净滤芯
海罗净杀菌技术采用溴原子与惰性高分子结合的技术,细菌或病毒只要接触了海罗净滤芯,几秒钟内即被杀灭。

溴原子舍身杀菌,一年或5000L水的洗礼,就消耗殆尽。

海罗净杀菌滤芯
一种彻底、持久和有效的杀菌技术
杀灭细菌和病毒,
无需使用电力,
经济环保!
海罗净杀菌效果
实验室数据图表

• 在使用海罗净滤芯一年的寿命周期内,可以实现杀菌/病毒,同时确保持续杀菌/杀菌的效果稳定。数据显示,大肠杆菌和噬菌体病毒的数量可以减少到99.9%。


